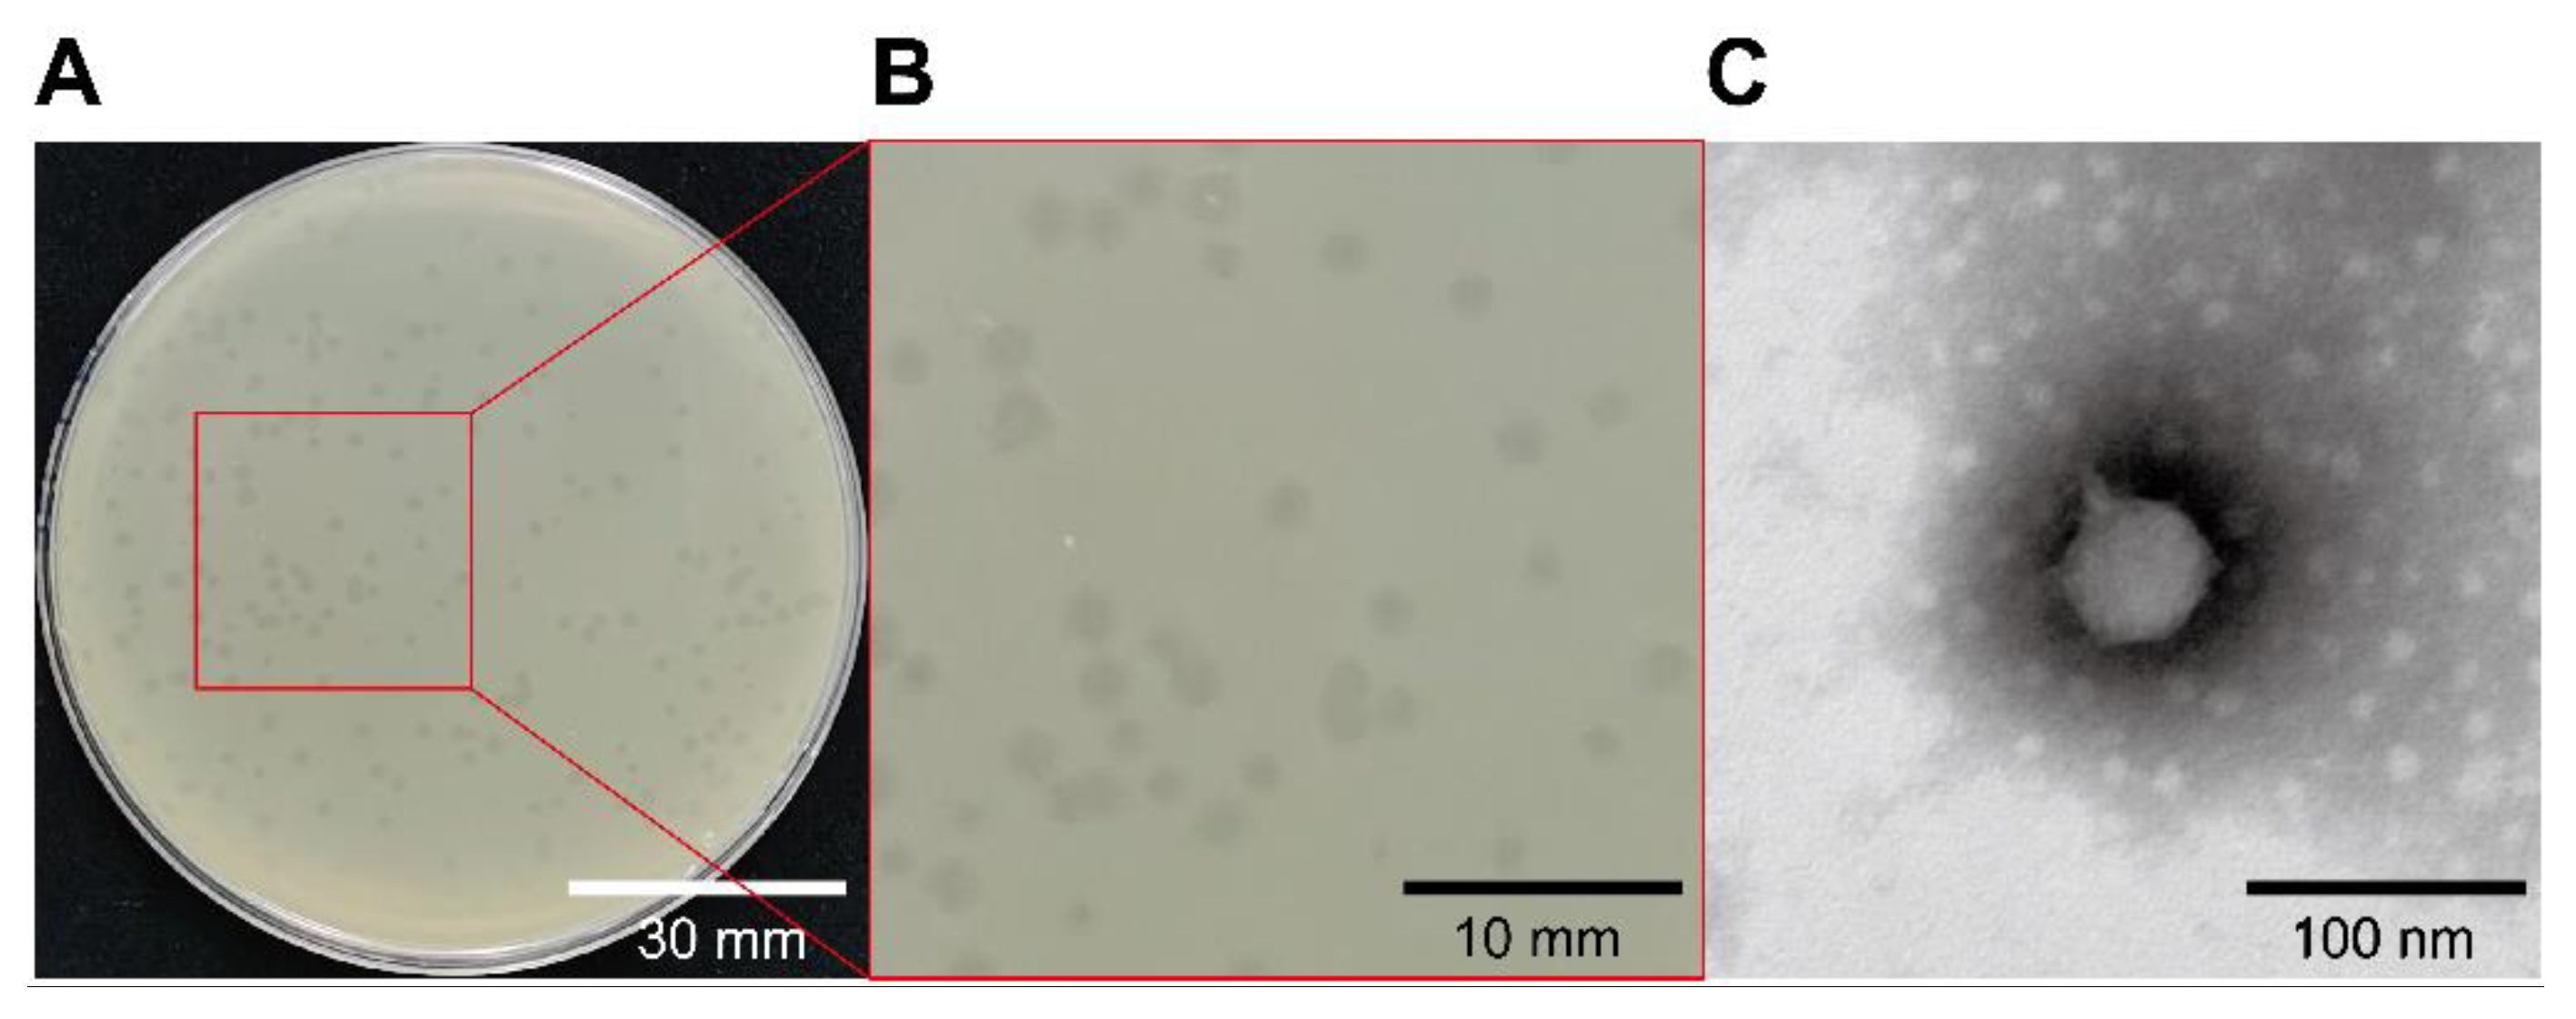

Isolation and Characterization of a Lytic Vibrio parahaemolyticus Phage vB_VpaP_GHSM17 from Sewage Samples
Abstract
:1. Introduction
2. Materials and Methods
2.1. Bacterial Strains and Phage Isolation
2.2. Phage Morphological Observation
2.3. Extraction and Sequencing of Phage Genome
2.4. Genome Assembly, Annotation, and Comparison
2.5. Phage Titer Determination
2.6. Determination of Phage Host Range
2.7. Determination of Multiplicity of Infection (MOI) and One-Step Growth
2.8. Stability of Phage to Environmental Stress
2.9. Phage Control Experiment
2.10. Statistical Analysis
3. Results
3.1. Morphology and Host Range of Bacteriophage GHSM17
3.2. Optimal MOI and One-Step Growth Curve
3.3. Stability of Bacteriophages
3.4. Bacterial Inhibition Assay
3.5. Characteristics of Phage Genome
4. Discussion
5. Conclusions
Supplementary Materials
Author Contributions
Funding
Institutional Review Board Statement
Informed Consent Statement
Data Availability Statement
Acknowledgments
Conflicts of Interest
References
- Kim, H.W.; Hong, Y.J.; Jo, J.I.; Ha, S.D.; Kim, S.H.; Lee, H.J.; Rhee, M.S. Raw ready-to-eat seafood safety: Microbiological quality of the various seafood species available in fishery, hyper and online markets. Lett. Appl. Microbiol. 2017, 64, 27–34. [Google Scholar] [CrossRef] [PubMed]
- Nishibuchi, M.; Fasano, A.; Russell, R.G.; Kaper, J.B. Enterotoxigenicity of Vibrio parahaemolyticus with and without genes encoding thermostable direct hemolysin. Infect. Immun. 1992, 60, 3539–3545. [Google Scholar] [CrossRef] [PubMed] [Green Version]
- Honda, T.; Ni, Y.X.; Miwatani, T. Purification and characterization of a hemolysin produced by a clinical isolate of kanagawa phenomenon-negative Vibrio parahaemolyticus and related to the thermostable direct hemolysin. Infect. Immun. 1988, 56, 961–965. [Google Scholar] [CrossRef] [Green Version]
- Li, L.; Meng, H.; Gu, D.; Li, Y.; Jia, M. Molecular mechanisms of Vibrio parahaemolyticus pathogenesis. Microbiol. Res. 2019, 222, 43–51. [Google Scholar] [CrossRef] [PubMed]
- Raghunath, P. Roles of thermostable direct hemolysin (TDH) and TDH-related hemolysin (TRH) in Vibrio parahaemolyticus. Front. Microbiol. 2014, 5, 805. [Google Scholar] [CrossRef]
- Ppa, B.; Bkb, A.; Pkdm, C.; Pkp, A. Virulence factor genes and comparative pathogenicity study of tdh, trh and tlh positive Vibrio parahaemolyticus strains isolated from whiteleg shrimp, Litopenaeus vannamei in India. Infect. Genet. Evol. 2021, 95, 105083. [Google Scholar]
- Kumar, R.; Ng, T.H.; Wang, H.C. Acute hepatopancreatic necrosis disease in penaeid shrimp. Rev. Aquac. 2020, 12, 1867–1880. [Google Scholar] [CrossRef] [Green Version]
- Elmahdi, S.; DaSilva, L.V.; Parveen, S. Antibiotic resistance of Vibrio parahaemolyticus and Vibrio vulnificus in various countries: A review. Food Microbiol. 2016, 57, 128–134. [Google Scholar] [CrossRef] [Green Version]
- Xie, T.; Wu, Q.; Xu, X.; Zhang, J.; Guo, W. Prevalence and population analysis of Vibrio parahaemolyticus in aquatic products from South China markets. FEMS Microbiol. Lett. 2015, 22, 362. [Google Scholar]
- Xie, T.; Xu, X.; Wu, Q.; Zhang, J.; Cheng, J. Prevalence, molecular characterization, and antibiotic susceptibility of Vibrio parahaemolyticus from ready-to-eat foods in China. Front. Microbiol. 2016, 7, 549. [Google Scholar] [CrossRef]
- Xie, T.; Wu, Q.; Zhang, J.; Xu, X.; Cheng, J. Comparison of Vibrio parahaemolyticus isolates from aquatic products and clinical by antibiotic susceptibility, virulence, and molecular characterisation. Food Control 2017, 71, 315–321. [Google Scholar] [CrossRef]
- Lesmana, M.; Subekti, D.; Simanjuntak, C.H.; Tjaniadi, P.; Campbell, J.R.; Oyofo, B.A. Vibrio parahaemolyticus associated with cholera-like diarrhea among patients in North Jakarta, Indonesia. Diagn. Microbiol. Infect. Dis. 2001, 39, 71–75. [Google Scholar] [CrossRef]
- Ottaviani, D.; Leoni, F.; Talevi, G.; Masini, L.; Santarelli, S.; Rocchegiani, E.; Susini, F.; Montagna, C.; Monno, R.; Annibale, L.D. Extensive investigation of antimicrobial resistance in Vibrio parahaemolyticus from shellfish and clinical sources, Italy. Int. J. Antimicrob. Agents 2013, 42, 191–193. [Google Scholar] [CrossRef] [PubMed]
- Kang, C.H.; Shin, Y.; Jang, S.C.; Yu, H.S.; Kim, S.K.; An, S.; Park, K.; So, J.S. Characterization of Vibrio parahaemolyticus isolated from oysters in Korea: Resistance to various antibiotics and prevalence of virulence genes. Mar. Pollut. Bull. 2017, 118, 261. [Google Scholar] [CrossRef] [PubMed]
- Yin, Y.; Liu, D.; Yang, S.; Almeida, A.; Guo, Q.; Zhang, Z.; Deng, L.; Wang, D. Bacteriophage potential against Vibrio parahaemolyticus biofilms. Food Control 2019, 98, 156–163. [Google Scholar] [CrossRef]
- Jamal, M.; Bukhari, S.M.; Andleeb, S.; Ali, M.; Raza, S.; Nawaz, M.A.; Shah, S.S. Bacteriophages: An overview of the control strategies against multiple bacterial infections in different fields. J. Basic Microbiol. 2019, 59, 123–133. [Google Scholar] [CrossRef]
- Sharma, S.; Chatterjee, S.; Datta, S.; Prasad, R.; Dubey, D.; Prasad, R.K.; Vairale, M.G. Bacteriophages and its applications: An overview. Folia Microbiol. 2017, 62, 17–55. [Google Scholar] [CrossRef]
- Sulakvelidze, A.; Alavidze, Z.; Morris, J.G. Bacteriophage therapy. Antimicrob. Agents Chemother. 2001, 45, 649–659. [Google Scholar] [CrossRef] [Green Version]
- D’Accolti, M.; Soffritti, I.; Mazzacane, S.; Caselli, E. Bacteriophages as a potential 360-degree pathogen control strategy. Microorganisms 2021, 9, 261. [Google Scholar] [CrossRef]
- Abuladze, T.; Li, M.; Menetrez, M.Y.; Dean, T.; Senecal, A.; Sulakvelidze, A. Bacteriophages reduce experimental contamination of hard surfaces, tomato, spinach, broccoli, and ground beef by Escherichia coli O157:H7. Appl. Environ. Microbiol. 2008, 74, 6230–6238. [Google Scholar] [CrossRef] [Green Version]
- Goode, D.; Allen, V.M.; Barrow, P.A. Reduction of experimental Salmonella and Campylobacter contamination of chicken skin by application of lytic bacteriophages. Appl. Environ. Microbiol. 2003, 69, 5032. [Google Scholar] [CrossRef] [PubMed] [Green Version]
- Sharma, M.; Patel, J.R.; Conway, W.S.; Ferguson, S.; Sulakvelidze, A. Effectiveness of bacteriophages in reducing Escherichia coli O157:H7 on fresh-cut cantaloupes and lettucet. J. Food Prot. 2009, 72, 1481. [Google Scholar] [CrossRef] [PubMed] [Green Version]
- Matamp, N.; Bhat, S.G. Phage endolysins as potential antimicrobials against multidrug resistant Vibrio alginolyticus and Vibrio parahaemolyticus: Current status of research and challenges ahead. Microorganisms 2019, 7, 84. [Google Scholar] [CrossRef] [PubMed] [Green Version]
- Nikapitiya, C.; Chandrarathna, H.; Dananjaya, S.; De Zoysa, M.; Lee, J. Isolation and characterization of phage (ETP-1) specific to multidrug resistant pathogenic Edwardsiella tarda and its in vivo biocontrol efficacy in zebrafish. Biologicals 2020, 63, 14–23. [Google Scholar] [CrossRef]
- Karunasagar, I.; Shivu, M.; Girisha, S.; Krohne, G.; Karunasagar, I. Biocontrol of pathogens in shrimp hatcheries using bacteriophages. Aquaculture 2007, 268, 288–292. [Google Scholar] [CrossRef]
- Chan, B.K.; Turner, P.E.; Samuel, K.; Mojibian, H.R.; Elefteriades, J.A.; Pak, N. Phage treatment of an aortic graft infected with Pseudomonas aeruginosa. Evol. Med. Public Health 2018, 2018, 60–66. [Google Scholar] [CrossRef] [Green Version]
- Tada, J.; Ohashi, T.; Nishimura, N.; Shirasaki, Y.; Ozaki, H.; Fukushima, S.; Takano, J.; Nishibuchi, M.; Takeda, Y. Detection of the thermostable direct hemolysin gene (tdh) and the thermostable direct hemolysin-related hemolysin gene (trh) of Vibrio parahaemolyticus by polymerase chain reaction. Mol. Cell. Probes 1992, 6, 477–487. [Google Scholar] [CrossRef]
- Bej, A.K.; Patterson, D.P.; Brasher, C.W.; Vickery, M.C.; Jones, D.D.; Kaysner, C.A. Detection of total and hemolysin-producing Vibrio parahaemolyticus in shellfish using multiplex PCR amplification of tlh, tdh and trh. J. Microbiol. Methods 1999, 36, 215–225. [Google Scholar] [CrossRef]
- Clokie, M.R.J.; Kropinski, A.M. Bacteriophage enrichment from water and soil. Methods Mol. Biol. 2009, 501, 15. [Google Scholar]
- Xing, S.; Zhang, X.; Sun, Q.; Wang, J.; Mi, Z.; Pei, G.; Huang, Y.; An, X.; Fu, K.; Zhou, L. Complete genome sequence of a novel, virulent ahjdlikevirus bacteriophage that infects Enterococcus faecium. Arch. Virol. 2017, 162, 3843–3847. [Google Scholar] [CrossRef]
- Luo, R.; Liu, B.; Xie, Y.; Li, Z.; Liu, Y. SOAPdenovo2: An empirically improved memory-efficient short-read de novo assembler. GigaScience 2012, 1, 2047-217X-1-18. [Google Scholar] [CrossRef] [PubMed]
- Coil, D.; Jospin, G.; Darling, A.E. A5-miseq: An updated pipeline to assemble microbial genomes from Illumina MiSeq data. Bioinformatics 2014, 31, 587–589. [Google Scholar] [CrossRef] [PubMed]
- Bankevich, A.; Nurk, S.; Antipov, D.; Gurevich, A.A.; Dvorkin, M.; Kulikov, A.S.; Lesin, V.M.; Nikolenko, S.I.; Pham, S.; Prjibelski, A.D. SPAdes: A new genome assembly algorithm and its applications to single-cell sequencing. J. Comput. Biol. 2012, 19, 455–477. [Google Scholar] [CrossRef] [PubMed] [Green Version]
- Altschul, S.; Gish, W.; Miller, W.; Myers, E.; Lipman, D. Basic local alignment search tool. J. Mol. Biol. 1990, 215, 403–410. [Google Scholar] [CrossRef]
- Walker, B.J.; Abeel, T.; Shea, T.; Priest, M.; Earl, A.M. Pilon: An integrated tool for comprehensive microbial variant detection and genome assembly improvement. PLoS ONE 2014, 9, e112963. [Google Scholar]
- Buchfink, B.; Xie, C.; Huson, D.H. Fast and sensitive protein alignment using diamond. Nat. Methods 2015, 12, 59–60. [Google Scholar] [CrossRef]
- John, B.; Alexandre, L.; Mark, B. GeneMarkS: A self-training method for prediction of gene starts in microbial genomes. Implications for finding sequence motifs in regulatory regions. Nucleic Acids Res. 2001, 29, 2607–2618. [Google Scholar]
- Kalvari, I.; Argasinska, J.; Quinones-Olvera, N.; Nawrocki, E.P.; Rivas, E.; Eddy, S.R.; Bateman, A.; Finn, R.D.; Petrov, A.I. Rfam 13.0: Shifting to a genome-centric resource for non-coding RNA families. Nucleic Acids Res. 2018, 46, 335–342. [Google Scholar] [CrossRef]
- Sullivan, M.J.; Petty, N.K.; Beatson, S.A. Easyfig: A genome comparison visualizer. Bioinformatics 2011, 27, 1009–1010. [Google Scholar] [CrossRef]
- Jain, C.; Rodriguez-R, L.M.; Phillippy, A.M.; Konstantinidis, K.T.; Aluru, S. High throughput ANI analysis of 90k prokaryotic genomes reveals clear species boundaries. Nat. Commun. 2018, 9, 5114. [Google Scholar] [CrossRef] [Green Version]
- Kolde, R.; Kolde, R.; Kolde, M.R. Pheatmap: Pretty heatmaps. R Package 2015, 1, 790. [Google Scholar]
- Shinohara, A.; Hara, H.; Kramp, K.; Blank, S.M.; Kameda, Y. Bird droppings on chestnut leaves or sawfly larvae: DNA barcodes verify the occurrence of the archaic Megaxyela togashii in Hokkaido, Japan. Zootaxa 2017, 4221, 6. [Google Scholar] [CrossRef] [PubMed]
- Yang, M.; Liang, Y.; Huang, S.; Zhang, J.; Tan, Z. Isolation and characterization of the novel phages vB_VpS_BA3 and vB_VpS_CA8 for lysing Vibrio parahaemolyticus. Front. Microbiol. 2020, 11, 259. [Google Scholar] [CrossRef]
- Ding, T.; Sun, H.; Pan, Q.; Zhao, F.; Ren, H. Isolation and characterization of Vibrio parahaemolyticus bacteriophage vB_VpaS_PG07. Virus Res. 2020, 286, 198080. [Google Scholar] [CrossRef] [PubMed]
- Alves, D.R.; Gaudion, A.; Bean, J.E.; Perez Esteban, P.; Arnot, T.C.; Harper, D.R.; Kot, W.; Hansen, L.H.; Enright, M.C.; Jenkins, A.T.A. Combined use of bacteriophage and a novel bacteriophage to reduce Staphylococcus aureus biofilm formation. Appl. Environ. Microbiol. 2014, 80, 6694–6703. [Google Scholar] [CrossRef] [PubMed] [Green Version]
- Ansaruzzaman, M.; Howdhury, A.C.; Bhuiyan, N.A.; Sultana, M.; Safa, A.; Lucas, M.; Von, S.L.; Barreto, A.; Chaignat, C.L.; Sack, D.A. Characteristics of a pandemic clone of O3: K6 and O4: K68 Vibrio parahaemolyticus isolated in Beira, Mozambique. J. Med. Microbiol. 2008, 57, 1502–1507. [Google Scholar] [CrossRef]
- Velazquez, R.J.; León-Sicairos, N.; Hernandez, D.J.; Canizalez, R.A. Pandemic Vibrio parahaemolyticus O3:K6 on the American continent. Front. Cell. Infect. Microbiol. 2014, 3, 110. [Google Scholar] [CrossRef] [Green Version]
- Han, C.; Tang, H.; Ren, C.; Zhu, X.; Han, D. Sero-prevalence and genetic diversity of pandemic V. parahaemolyticus strains occurring at a global scale. Front. Microbiol. 2016, 7, 567. [Google Scholar] [CrossRef] [Green Version]
- Hara-Kudo, Y.; Saito, S.; Ohtsuka, K.; Yamasaki, S.; Yahiro, S.; Nishio, T.; Iwade, Y.; Otomo, Y.; Konuma, H.; Tanaka, H. Characteristics of a sharp decrease in Vibrio parahaemolyticus infections and seafood contamination in Japan. Int. J. Food Microbiol. 2012, 157, 95–101. [Google Scholar] [CrossRef]
- Chan, B.K.; Abedon, S.T.; Loc, C.C. Phage cocktails and the future of phage therapy. Future Microbiol. 2013, 8, 769–783. [Google Scholar] [CrossRef]
- Housby, J.N.; Mann, N.H. Phage therapy. Drug Discov. Today 2009, 14, 536–540. [Google Scholar] [CrossRef] [PubMed]
- Lang, L.H. FDA approves use of bacteriophages to be added to meat and poultry products. Gastroenterology 2006, 131, 1370. [Google Scholar] [CrossRef] [PubMed]
- Yang, M.; Chen, H.; Guo, S.; Tan, S.; Xie, Z.; Zhang, J.; Wu, Q.; Tan, Z. Characterization and genome analysis of a novel Vibrio parahaemolyticus phage vB_VpP_DE17. Virus Res. 2022, 307, 198580. [Google Scholar] [CrossRef] [PubMed]
- Le, T.S.; Southgate, P.C.; O’Connor, W.; Abramov, T.; Shelley, D.; Vu, S.; Kurtböke, D.İ. Use of bacteriophages to control Vibrio contamination of microalgae used as a food source for oyster larvae during hatchery culture. Curr. Microbiol. 2020, 77, 1811–1820. [Google Scholar] [CrossRef] [PubMed]
- Cao, Y.; Zhang, Y.; Lan, W.; Sun, X. Characterization of vB_VpaP_MGD2, a newly isolated bacteriophage with biocontrol potential against multidrug-resistant Vibrio parahaemolyticus. Arch. Virol. 2021, 16, 413–426. [Google Scholar] [CrossRef]
- Dubey, S.; Singh, A.; Kumar, B.; Singh, N.K.; Tyagi, A. Isolation and characterization of bacteriophages from inland saline aquaculture environments to control Vibrio parahaemolyticus contamination in shrimp. Indian J. Microbiol. 2021, 61, 212–217. [Google Scholar] [CrossRef]
- Wong, H.; Wang, T.Y.; Yang, C.W.; Tang, C.T.; Ying, C.; Wang, C.H.; Chang, W.H. Characterization of a lytic vibrio phage VP06 of Vibrio parahaemolyticus. Res. Microbiol. 2019, 17, 13–23. [Google Scholar] [CrossRef]
- Olszak, T.; Latka, A.; Roszniowski, B.; Valvano, M.A.; Drulis, K.Z. Phage life cycles behind bacterial biodiversity. Curr. Med. Chem. 2017, 24, 3987–4001. [Google Scholar] [CrossRef] [Green Version]
- Kaźmierczak, Z.; Górski, A.; Dąbrowska, K. Facing antibiotic resistance: Staphylococcus aureus phages as a medical tool. Viruses 2014, 6, 2551–2570. [Google Scholar] [CrossRef] [Green Version]
- Yu, J.; Lim, J.A.; Kwak, S.J.; Park, J.H.; Chang, H.J. Comparative genomic analysis of novel bacteriophages infecting Vibrio parahaemolyticus isolated from western and southern coastal areas of Korea. Arch. Virol. 2018, 163, 1337–1343. [Google Scholar] [CrossRef]
- Hu, M.; Zhang, H.; Gu, D.; Ma, Y.; Zhou, X. Identification of a novel bacterial receptor that binds tail tubular proteins and mediates phage infection of Vibrio parahaemolyticus. Emerg. Microbes Infect. 2020, 9, 855–867. [Google Scholar] [CrossRef] [PubMed] [Green Version]
- Bastías, R.; Higuera, G.; Sierralta, W.; Espejo, R.T. A new group of cosmopolitan bacteriophages induce a carrier state in the pandemic strain of Vibrio parahaemolyticus. Environ. Microbiol. 2010, 12, 990–1000. [Google Scholar] [CrossRef] [PubMed]
- Nobrega, F.L.; Vlot, M.; Jonge, P.; Dreesens, L.L.; Beaumont, H.; Lavigne, R.; Dutilh, B.E.; Brouns, S. Targeting mechanisms of tailed bacteriophages. Nat. Rev. Microbiol. 2018, 16, 760–773. [Google Scholar] [CrossRef] [PubMed]
- Maciejewska, B.; Olszak, T.; Drulis, K.Z. Applications of bacteriophages versus phage enzymes to combat and cure bacterial infections: An ambitious and also a realistic application? Appl. Microbiol. Biotechnol. 2018, 102, 2563–2581. [Google Scholar] [CrossRef] [Green Version]

| Strain | Origin | Lytic Ability | Virulence Genes |
|---|---|---|---|
| V. parahaemolyticus ATCC17802 | American Type Culture Collection | + | Tlh+/tdh−/trh+ |
| V. parahaemolyticus PR13 | Pearl River | − | tlh+/tdh−/trh− |
| V. parahaemolyticus OY14 | American Oysters | + | tlh+/tdh−/trh− |
| V. parahaemolyticus FFTF11 | Frozen Fork Tail Fillets | + | tlh+/tdh−/trh− |
| V. parahaemolyticus BC21 | Bengali Frozen Cuttlefish | − | tlh+/tdh−/trh− |
| V. parahaemolyticus BC20 | Bengali Frozen Cuttlefish | + | tlh+/tdh−/trh− |
| V. parahaemolyticus IFH23 | Indonesian Frozen Hairtail | − | tlh+/tdh−/trh− |
| V. parahaemolyticus TGS36 | Thai Grass Shrimp | + | tlh+/tdh−/trh− |
| V. parahaemolyticus SAL38 | South African Lobster | − | tlh+/tdh−/trh− |
| V. parahaemolyticus HA44 | Haliotis | − | tlh+/tdh−/trh− |
| V. parahaemolyticus CR48 | Crab | + | tlh+/tdh−/trh− |
| V. parahaemolyticus OY49 | Oyster | + | tlh+/tdh−/trh− |
| V. parahaemolyticus TMS61 | Thai Mantis Shrimp | − | tlh+/tdh−/trh− |
| V. parahaemolyticus SC123 | Scallop | + | tlh+/tdh−/trh− |
| V. parahaemolyticus SC126 | Scallop | − | tlh+/tdh−/trh− |
| V. parahaemolyticus CR127 | Crab | + | tlh+/tdh−/trh− |
| V. parahaemolyticus SE132 | Seawater | − | tlh+/tdh−/trh− |
| Phage | Len. (bp) | GC (%) | ORFs | tRNA | Termini | Type |
|---|---|---|---|---|---|---|
| vB_VpaP_GHSM17 | 43,228 | 49.42 | 45 | 0 | direct terminal repeat | linear |
Publisher’s Note: MDPI stays neutral with regard to jurisdictional claims in published maps and institutional affiliations. |
© 2022 by the authors. Licensee MDPI, Basel, Switzerland. This article is an open access article distributed under the terms and conditions of the Creative Commons Attribution (CC BY) license (https://creativecommons.org/licenses/by/4.0/).
Share and Cite
Liang, X.; Wang, Y.; Hong, B.; Li, Y.; Ma, Y.; Wang, J. Isolation and Characterization of a Lytic Vibrio parahaemolyticus Phage vB_VpaP_GHSM17 from Sewage Samples. Viruses 2022, 14, 1601. https://doi.org/10.3390/v14081601
Liang X, Wang Y, Hong B, Li Y, Ma Y, Wang J. Isolation and Characterization of a Lytic Vibrio parahaemolyticus Phage vB_VpaP_GHSM17 from Sewage Samples. Viruses. 2022; 14(8):1601. https://doi.org/10.3390/v14081601
Chicago/Turabian StyleLiang, Xunru, Yuhang Wang, Bin Hong, Yanmei Li, Yi Ma, and Jufang Wang. 2022. "Isolation and Characterization of a Lytic Vibrio parahaemolyticus Phage vB_VpaP_GHSM17 from Sewage Samples" Viruses 14, no. 8: 1601. https://doi.org/10.3390/v14081601
APA StyleLiang, X., Wang, Y., Hong, B., Li, Y., Ma, Y., & Wang, J. (2022). Isolation and Characterization of a Lytic Vibrio parahaemolyticus Phage vB_VpaP_GHSM17 from Sewage Samples. Viruses, 14(8), 1601. https://doi.org/10.3390/v14081601

